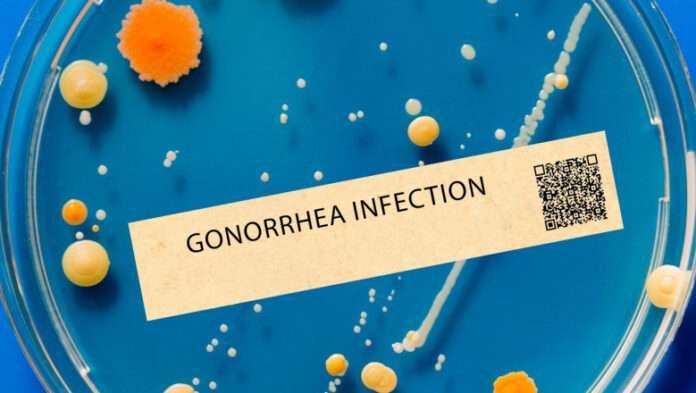

În Republica Moldova, infecțiile cu transmitere sexuală sunt monitorizate prin Programul Național de Prevenire și Control al Infecției HIV/SIDA și al Infecțiilor cu Transmitere Sexuală pentru anii 2022-2025. Conform datelor Ministerului Sănătății, în 2022 au fost raportate 274 de cazuri de ITS, dintre care 262 de cazuri de sifilis și 12 de gonoree.
Deși datele specifice pentru 2024 nu sunt încă disponibile publicului, tendințele europene sugerează o posibilă creștere și în Republica Moldova. Factorii care contribuie la această situație includ schimbările în comportamentele sexuale, lipsa educației sexuale adecvate și accesul limitat la metode de protecție. Un studiu UNICEF arată că doar 36% dintre fete și 28% dintre băieții cu vârste între 15 și 24 de ani din Moldova cunosc modalitățile de transmitere și protecție împotriva HIV, ceea ce indică o nevoie urgentă de educație sexuală mai eficientă.
Infecțiile cu transmitere sexuală (ITS) sunt în creștere alarmantă în Europa, iar Republica Moldova nu face excepție de la această tendință. Conform celor mai recente date publicate de Centrul European pentru Prevenirea și Controlul Bolilor (ECDC), cazurile de gonoree și sifilis s-au triplat în mai puțin de un deceniu, atingând niveluri record.
Situația ITS în Europa: creșteri record
Potrivit ECDC, în 2023, aproape 100.000 de cazuri confirmate de gonoree au fost raportate în Europa, marcând o creștere de 31% față de 2022 și o creștere de peste 300% comparativ cu 2014. Aceasta reprezintă cea mai mare rată înregistrată de la începerea supravegherii ITS de către ECDC, în 2009.
De asemenea, cazurile de sifilis au continuat să crească, cu 40.000 de cazuri confirmate în 2023, ceea ce reprezintă o creștere de 13% față de 2022 și o dublare a numărului de cazuri din 2014. Chlamydia rămâne cea mai frecvent raportată ITS bacteriană, cu peste 230.000 de cazuri în 2023, deși ritmul de creștere a acestora pare să fi încetinit.
Specialiștii avertizează și asupra creșterii rezistenței antimicrobiene la gonoree, ceea ce face tratamentele actuale mai puțin eficiente. Un alt factor important care contribuie la această tendință este schimbarea comportamentelor sexuale, inclusiv utilizarea mai redusă a prezervativelor. Organizația Mondială a Sănătății (OMS) a tras un semnal de alarmă cu privire la faptul că adolescenții din Europa folosesc tot mai puțin prezervative, ceea ce crește riscul de ITS și sarcini nedorite.
Măsuri necesare pentru prevenire
Pentru a combate această problemă de sănătate publică, autoritățile din Republica Moldova au implementat programe naționale axate pe prevenire, testare și tratament. Totuși, succesul acestor inițiative depinde în mare măsură de conștientizarea publicului și de adoptarea unor practici sexuale responsabile.
Specialiștii recomandă intensificarea campaniilor de informare, promovarea utilizării prezervativelor și accesul facilitat la servicii medicale pentru testare și tratament. De asemenea, educația sexuală în școli poate juca un rol esențial în reducerea numărului de cazuri și prevenirea complicațiilor pe termen lung.
Datele recente subliniază necesitatea unor acțiuni imediate pentru a preveni o criză de sănătate publică mai amplă și pentru a proteja populația de efectele pe termen lung ale acestor infecții.